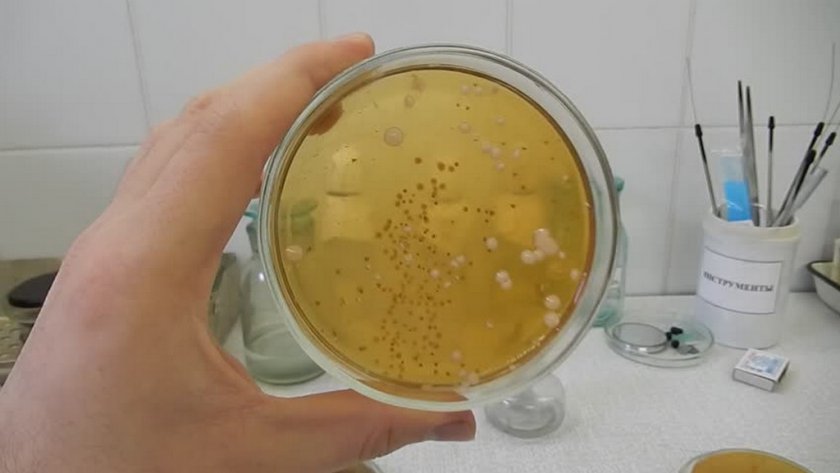

Общий анализ мочи — это первое, что требуется сдать для определения состояния здоровья, особенно если речь идёт об органах брюшной полости и малого таза животного или человека. Наряду с общим анализом крови данное исследование актуально практически при любом заболевании, хотя нередко его проводят и в профилактических целях, когда нужно убедиться в хорошем здоровье питомца. Как правильно собрать мочу собаки, что подразумевает её исследование и на какие важные критерии врачи обращают внимание в ходе его проведения — об этом далее.
Как проходит анализ мочи у собак
Готовые результаты анализов мочи у собак предоставляют данные сразу по нескольким критериям, поэтому, чтобы получить нужную информацию, оценивают физико-химические характеристики образца биоматериала и микроскопию осадка. Каждый вариант имеет большое информационное значение в диагностике различных заболеваний.
По физико-химическим характеристикам
Основными физико-химическими характеристиками мочи будут её количество, цвет, запах, плотность, уровень рН, наличие белка, сахара, кетоновых тел и других составляющих компонентов. Чтобы полученные результаты были максимально достоверными, оценку по всем критериям нужно давать в течение 1–1,5 часов после забора жидкости в чистую ёмкость.
Для определения реакции мочи (рН) используют индикаторы универсальной бумаги. Жёлтый цвет свидетельствует о кислой реакции, бурый — о слабокислой, сине-зелёный — слабо-щелочной, травянистый — нейтральной, зелёный или ярко-синий — щелочной.
Цвет биоматериала определяется в проходящем свете, слегка приподняв лабораторную ёмкость на уровень глаз (в качестве фона обычно используется белый листок бумаги). При отсутствии патологий моча у животных должна быть жёлтой, во всех оттенках: начиная от соломенного и заканчивая канареечным. Если жидкость мутная, а не прозрачная — её дополнительно исследуют в процессе проведения микроскопии осадка. Уровень мутности определяется путём смещения цилиндра с жидкостью в сторону какого-либо предмета, находящегося на чёрном фоне.
Запах образца определяют органолептически, и в норме он не должен быть резким. Аромат аммиака свидетельствует развитии цистита, пиелонифрита и пиелита.
Показатель плотности органической жидкости устанавливают с помощью урометра, предварительно поместив образец в цилиндр. После остановки колебаний сухого инструмента показания снимают по нижнему мениску.
Присутствие белка в образце определяют одним из качественных методов (кольцевой пробой Геллера или кипячением), полуколичественным (например, с помощью специальных тест-полосок) или количественным способами (турбидиметрические, колориметрические).
Микроскопия осадка
В норме в моче здорового животного может находиться минимальное количество клеток, отслоившихся от стенок лоханки печени, мочевого пузыря, мочеточника и уретры, а также ограниченное количество лейкоцитов, которых при воспалении в организме становится в разы больше. Чтобы определить в норме эти значения или нет, проводится микроскопия осадка, для чего отобранный образец мочи изучают на стекле под микроскопом. В ходе такого исследования удаётся определить и кристаллы солей, вместе с белковыми цилиндрами, которые так же указывают на наличие какой-либо проблемы в организме собаки.
Нормальные показатели
Чтобы распознать патологию, при изучении отобранных образцов мочи у собаки необходимо знать показатели нормы для каждого отдельного критерия. Только сопоставив с ними полученный результат анализов, врачи могут определить степень несоответствия и задуматься о причинах такого явления.
Значения нормы по основным физико-химическим показателям описаны в таблице:
| Критерий оценки | Норма | Возможное отклонение |
| Цвет | Жёлтый или светло-жёлтый, с возможным небольшим потемнением из-за воздействия отдельных медикаментозных средств или продуктов питания (например, свеклы) | Красновато-коричневый, белый, зеленоватый или пивной оттенок биоматериала, что может указывать на примеси крови, гноя, или повышенное содержание лейкоцитов в образце |
| Прозрачность (присутствие осадка) | Полностью прозрачная моча | Помутнение связано с присутствием солей, бактерий и эпителиальных частиц |
| Запах | Слабовыраженный | Ацетоновый аромат может указывать на развитие сахарного диабета, а аммиака — на присутствие в организме инфекции |
| Плотность | 1,015–1,034 г/л, с возможным повышением до 1,065 г/л | Значения выше нормы свидетельствуют о присутствии в образце большого количества белка, глюкозы и компонентов принимаемых собакой лекарственных препаратов. При пониженных показателях можно заподозрить хроническую почечную недостаточность или острое поражение этого органа |
| Кислотность (реакция ph) | Слабо-кислая или слабо-щелочная, 5–7,5 единиц | Щелочная реакция указывает на проблемы с мочевым пузырём и мочевыводящими путями |
| Белок | Отсутствует | Положительный результат протеинурии (обнаружение белка в моче) свидетельствует о сильных физических нагрузках животного, судорожных приступах, патологиях организма, в частности воспалении мочевыводящих путей, сахарном диабете, анемии и хронических инфекциях |
| Глюкоза | 0,0 – 1,5 ммоль/л | Повышение нормальных значений говорит о большом количестве углеводной пищи в рационе, диабете, панкреатите, почечной недостаточности, тяжёлых травмах |
| Билирубин | Отсутствует | Повышается при недугах печени и желчевыводящих протоков |
| Лейкоциты | Отсутствуют или попадаются единичные в поле зрения | Повышенное количество указывает на инфекционный процесс в организме собаки |
Частицы эпителия, кристаллы, слизь и цилиндры так же могут быть замечены в анализе мочи здоровой собаки, но все они должны быть единичными, а повышение количества данных элементов свидетельствует о поражении почек, мочевыводящих протоков или о нарушении правил забора анализов. Подтверждением последнего может стать и появление в биоматериале большого количества бактерий, конечно, если врач может исключить вероятность развития инфекционного процесса.
Расшифровка анализа мочи у собак
Конкретных причин повышения или понижения нормальных показателей плотности, цвета и количества основных составляющих мочи может быть очень много, поэтому, чтобы определить наличие того или иного расстройства в организме собаки врач должен тщательно изучить все полученные результаты и знать об основных причинах их отклонения от нормальных данных. В этих целях и проводится детальная расшифровка анализов мочи по физическим, химическим и микроскопическим показателям, что позволяет подобрать адекватное лечение в дальнейшем.

Физические исследования
Физические исследования собранного анализа мочи основываются на изучении количественных показателей биоматериала, его цвета, запаха, прозрачности и плотности. Наличие или большое скопление отдельных компонентов (например, кокков, белка, эритроцитов, бактерий или лейкоцитов) способно повышать или, наоборот, понижать нормальные показатели физических характеристик, причём в каждом отдельном случае, возможно, своё нарушение в деятельности организма.
С чем связано изменение нормы для каждого указанного критерия оценки, описано в таблице.
| Критерий оценки | Причины изменения нормальных значений и возможные нарушения в работе организма |
| Количество мочи (20–50 мл/кг в сутки) | Повышение нормальных значений может указывать на отёчность, сахарный диабет, пиелонефрит, амилоидоз, новообразования, заболевания матки у сук, гипертериоз, болезни печени, синдром Кушинга, хроническую почечною недостаточность, психогенную тягу к питью, гиперкальциемию.
Основаниями для сниженных показателей будут профузный понос, рвота, недостаточное поступление жидкости, нарушенная работа почек или мочеполовой системы, что способствует накоплению жидкости внутри организма и её затрудненному отводу наружу. Причинами полного отсутствия мочеиспускания могут служить преренальная анурия, острая сердечная или сосудистая недостаточность, тяжёлые кровопотери, сильные приступы рвоты и поноса, острые нефриты, некронефрозы, тяжёлые хронические заболевания почек, наличие больших камней в мочевыводящих каналах, их сдавливание опухолями |
| Плотность (в норме 1,015–1,034 г/л) | Повышенные значения плотности указывают на присутствие в моче глюкозы, белка, остатка лекарственных препаратов: например, маннитола или декстранна при внутривенном вливании.
Снижение показателей наблюдается при остром поражении почек или хронической почечной недостаточности, сахарном диабете |
| Прозрачность (в норме полная) | Мутный образец может объясняться присутствием в образце большого количества эритроцитов, лейкоцитов, эпителиальных клеток, бактерий, слизи и жировых капель, осадка солей |
| Запах (слабовыраженный) | Ацетонурия при сахарном диабете, аммиачный аромат, вызванный бактериальными инфекциями, лекарственный запах из-за приёма антибиотиков или других сильнодействующих средств |
Изменение нормального соломенно-жёлтого цвета мочи на красный или красновато-коричневый часто оказывается признаком гемоглобинурии, макрогематурии, наличия в моче миоглобина, порфирина или остатков лекарственных препаратов. Тёмно-жёлтый цвет, иногда с зеленоватым оттенком, свидетельствует о выделении вместе с мочой билирубина, что характерно для желтухи паренхиматозного или механического типа. Зелёно-жёлтой моча становится при скоплении гноя в результате развития бактериальных процессов в органах мочеполовой системы или брюшной полости. Грязно-коричневый или серый цвет — признак полиурии или щелочной реакции мочи, тёмный или даже почти чёрный — гемоглобинурии при острой гемолитической анемии. В белый цвет мочу окрашивает большое количество фосфатов, что актуально при развитии фосфатурии.
Химические
Среди химических показателей, наиболее важными при анализе мочи у собак будут её кислотность, наличие белка, глюкозы, билирубина, уробилиногена, кетоновых тел, нитритов, эритроцитов, лейкоцитов и некоторых других компонентов мочи.
Причины возможных отклонений от нормы приведены в таблице.
| Критерий оценки | Причины изменения нормальных значений и возможные нарушения в работе организма |
| Кислотность (в норме рН 5–7,5) | Повышенные показатели обычно связаны с употреблением большого количества растительной пищи или же гиперкалиемией, процессом рассасывания отёков, первичным и вторичным гиперпаратиреозом, метаболическим, либо респираторным алкалозом, циститом бактериального происхождения, введением в лечебных целях бикарбоната натрия
Снижение показателей (закисление мочи) является результатом метаболического или респираторного ацидоза, гипокалиемии, обезвоживания организма, лихорадки, голодания, хронической почечной недостаточности, продолжительной мышечной нагрузки, сахарного диабета, применения в лечении кислых солей, вроде хлорида аммония |
| Белок (в норме он отсутствует или его концентрация меньше 100 мг/л) | Появление этого компонента может быть связано с физиологической протеинурией из-за применения кормов с повышенным содержанием белка, сильных физических нагрузок, эпилептических приступов, хотя не стоит исключать вероятность сердечной недостаточности, анемии, сахарного диабета, гемоглобинурией, внепочечной постренальной и почечной протеинурией, почечной микроальбуминурии, парапротеинурии, тубулярной протеинурии, ложных положительных и отрицательных показателей данного компонента из-за низкокачественных тест-полосок |
| Глюкоза (в норме не содержится в моче) | Основанием для появления в биоматериале служит сахарный диабет, первичная почечная глюкозория, использование нефротоксичных лекарств, острая почечная недостаточность, введение глюкозы в терапевтических целях, ложноотрицательный результат из-за присутствия повышенного количества аскорбиновой кислоты во время использования тест-полосок (синтезируется у собак в разном количестве) |
| Билирубин (в норме в моче могут присутствовать только его следы) | Повышенное содержание в образце указывает на паренхиматозную или обтурационную желтуху, вызванную нарушением оттока желчи |
| Уробилиноген (в норме до 10 мг/л) | Причины повышения нормальных значений: увеличение катаболизма гемоглобина, энтероколит, илеит, холангит, гепатит и цирроз печени, вторичная печеночная недостаточность, шунтирование печени при циррозе с портальной гипертензией, тромбозах |
| Кетоновые тела (должны отсутствовать) | Появляются в случае церебральной комы, длительного голодания, тяжёлой лихорадки, гиперкетонемической диабетической или цереральной комы, прекоматозных состояний, гиперинсулинизма, в послеоперационный период |
| Нитриты (должны отсутствовать) | Их наличие в анализе указывает на инфицирование мочевыводящих путей. В группу риска попадают собаки с опухолями простаты, животные, страдающие от сахарного диабета и питомцы, перенёсшие урологические операции или инструментальные процедуры |
| Эритроциты (до 3 штук в 1 мкл мочи) | Повышение эритроцитов в биоматериале (больше 5 шт. на 1 мкл мочи) может наблюдаться в результате формирования камней в мочевом пузыре и мочеиспускательном канале, цистите разной природы, опухолях и травмах мочевого пузыря, уретрите, повреждений, воспаления или формирования новообразований в почках |
| Гемоглобин и миоглобин (при диагностике тест-полосками должны отсутствовать) | Положительный результат анализа указывает на развитие гемолитической анемии, кровепаразитарных болезней, повреждение мышц, гематурии |
Что именно является причиной изменения нормальных параметров мочи — сложно сказать без дополнительных обследований, но отклонение от нормы сразу по нескольким критериям оценки может существенно сузить круг поиска проблемы. Зачастую присутствие или повышенное количество вышеперечисленных компонентов связано с нарушениями в работе почек, мочеполовой и эндокринной системы, хотя в список причин могут попасть и расстройства системы пищеварения или других органов.

Микроскопические
При изучении образца под микроскопом лаборанты выделяют составляющие организованного и неорганизованного типов осадков. В первом случае главными составляющими выступают лейкоциты, эритроциты, эпителий и цилиндры, а во втором под микроскопом хорошо заметны соли кристаллического и аморфного происхождения. Отклонение от нормы всех показателей свидетельствует о наличии того или иного заболевания в собачьем организме, поэтому так важно полностью расшифровать результаты и после проведения микроскопического исследования.
Возможные причины изменения нормальных показателей и связанные с ним болезни приведены в таблице.
| Критерий оценки | Причины изменения нормальных значений и возможные нарушения в работе организма |
| Эпителий (должны быть единичными в поле зрения) | Повышенное количество данных компонентов может быть связано с острой воспалительной активностью в мочевом пузыре и лоханках почек, интоксикацией организма, новообразованиями в мочевыводящих каналах, нефритом, ограниченностью кровообращения, некротическим нефрозом, амилоидозом почек, липоидным нефрозом. Низкий уровень или даже полное отсутствие эпителия в образце мочи не должно настораживать врачей |
| Лейкоциты (должны отсутствовать, либо не превышать 3 шт. в поле зрения) | Причинами пиурии (повышение нормы до более чем 60 лейкоцитов) может стать воспаление в уретре, мочевом пузыре или лоханке почек. Основания для развития лейкоцитурии (больше 3 лейкоцитов) — амилоидоз, наличие гломерулонефритов, хронический интерстициальный нефрит |
| Эритроциты (в норме 0-3 в поле зрения) | Увеличение допустимого количества в образце обычно указывает на формирование камней в мочевыводящих каналах, воспаление мочевого пузыря или появление в мочеполовой системе каких-либо новообразований. Присутствие эритроцитов может свидетельствовать и о наличии опухолей в почках |
| Цилиндры (в норме заметны единичные гиалиновые и зернистые) | Возможными причинами повышенного количества гиалиновых элементоы выступают лихорадка, протеинурия, органические поражения почек, обезвоживание. Зернистых цилиндров становится больше в результате дегенеративных процессов в эпителии мочевыводящих канальцев. Эритроцитарные формируются из скоплений эритроцитов в результате воспалительной активности в почках, кровотечений в их паренхиму и инфарктов данного органа. Лейкоцетарные цилиндры — обычно результат пиелонефритов |
| Соли и другие элементы | При закислении мочи в образце появляются мочевая кислота, мочекислые соли, соли кальция фосфата и сернокислого кальция. В щелочном биоматериале обнаруживаются аморфные фосфаты, трипельфосфаты, нейтральный магния фосфат, кристаллы сульфиниламидов, кальций карбонат. Мочевой кислоты в собачьей моче быть не должно, в противном случае можно задуматься о вероятности почечной недостаточности, лихорадке, пневмонии, лейкозе, мочекислом диатезе или неправильном питании, с присутствием в рационе только мясных продуктов. Аморфные ураты появляются при остром и хроническом гломерулонефрите, хронической почечной недостаточности, лихорадке. Соли щавелевой кислоты актуальны при пиелонефрите, сахарном диабете, нарушениях кальциевого обмена, отравлении этиленогликолем. Нейтральные фосфаты обычно проявляются из-за цистита, рвоты, большого количества растительной пищи в рационе. Кристаллы цистина указывают на врождённое расстройства обменных процессов кислот в организме, а тирозина и лейцина — на острую жёлтую атрофию печени, лейкоз и отравление фосфором. Холистериновые кристаллы — вероятный признак новообразований в почках, их дистрофии или абсцесса. При отсутствии патологий должны отсутствовать продукты распада гемоглобина, а вот их наличие указывает на анемию, абсцессы или опухоли почек |
| Бактерии (отсутствуют или диагностируются в количестве не больше 2х103 бакт.\мл мочи) | Превышение допустимой нормы свидетельствует о воспалительной активности в мочевыводящих органах или же о неправильном сборе биоматериала (менее 1000 микробов на 1 мл мочи). Подтверждением наличия инфекции будут одновременно обнаруженные бактериурия, гематурия и пиурия |
| Дрожжевые грибки (в норме не видны) | Причинами их появления в анализе обычно служат глюкозурия, лечение антибиотиками, продолжительное хранение собранной мочи |
Получить полную картину состояния здоровья собаки можно только при тщательном анализе всех полученных результатов исследования. Большинство составляющих мочи связаны между собой, поэтому наличие сразу нескольких элементов, подтверждающих воспалительный процесс, не дадут усомниться в истинности таких предположений. По этой причине, в дополнение к общему анализу мочи врачи часто рекомендуют сдать ещё и бактериальный посев, особенно если первичное обследование уже показало наличие патогенной микрофлоры.
Когда нужно сдавать анализ мочи собакам
Основным показанием к сдаче мочи будут заболевания почек и органов мочеполовой системы, причём даже в том случае, если у врачей есть только подозрения на этот счёт. В некоторых ситуациях данный анализ выступает дополнительным диагностическим методом, использующимся в комплексе с общим или биохимическим анализом крови.
Прямыми показаниями к нему будут такие изменения в здоровье собаки:
- учащённое мочеиспускание;
- повышенная температура тела без видимых на то причин;
- появление в моче сгустков, вкраплений крови или примесей гноя;
- покраснение и опухание наружных половых органов;
- заболевания желудочно-кишечного тракта, выражающиеся, например, в частых запорах, болезненности внутренних органов при пальпации через брюшную стенку;
- плановое обследование собаки, особенно если в прошлом у неё имелись расстройства в работе мочеполовой системы.
Собакам до 5–7 лет жизни рекомендуется сдавать мочу не реже 1-2 раз в год, но чем старше становится питомец, тем чаще стоит проходить подобное обследование.
Что нужно для сбора мочи
Мочу на анализ сдают в специальной чистой ёмкости (пробирке или пластиковой баночке), которую можно приобрести в аптеке. Однако небольшая тара неудобна для непосредственного забора жидкости, поэтому некоторые владельцы используют в этих целях разрезанную пластиковую бутылку или даже пластиковые широкие лотки и пакеты, главное — чтобы они были максимально чистыми. В дальнейшем собранную мочу переливают в аптечные баночки и доставляют в лабораторию не позже, чем через 2 часа после забора, в противном случае нельзя надеяться на достоверные результаты анализа.
В специализированных зооаптеках продаются наборы для забора собачьей мочи. Ими удобно пользоваться при взаимодействии с крупными питомцами, так как входящие в комплект небольшой лоток, пипетка и стерильный контейнер позволяют без проблем собрать биоматериал и перелить его в лабораторную ёмкость. Для взятия образца у маленьких собачек, вместо лотка используют небольшой пакетик с ручками, скатанный и привязанный к собаке так, чтобы он не доставлял дискомфорта, но при этом покрывал наружные половые органы. После того, как питомец сходит в туалет останется только перелить мочу из пакета в стандартную пробирку с помощью шприца.
Из дополнительных приспособлений понадобятся тазик с тёплой водой и чистая вата для очистки половых органов перед сбором мочи
Как правильно собрать материал для сдачи
Общими требованиями для сбора мочи у собак любого пола будет использование только чистой тары, предварительная очистка наружных половых органов и выполнение всех манипуляций в утренние часы. За сутки до этого нельзя давать животному острую или жирную пищу, поскольку это отрицательно скажется на достоверности результата исследования. Некоторые отличия в проведении забора жидкости объясняются разной половой принадлежностью домашних питомцев, поэтому тут стоит учитывать дополнительные нюансы сбора биоматериала.
У кобелей
Чтобы получить нужный образец, придётся воспользоваться обрезанной бутылкой или же прикрепить к половому органу животного специальный контейнер. Некоторые владельцы надевают на кобелей презервативы для УЗИ или обычные пакетики, заранее прикрепив к ним ручки для удобной фиксации на спине. После наполнения резервуара останется только перелить собранную мочу в подготовленную тару. Конечно, не всем собакам понравится такое приспособление между лапами, поэтому вполне вероятно, что хозяину придётся вернуться к методу с бутылкой.
У сук
Для сбора мочи у крупных и средних по размерам сук отлично подойдёт чистый пластиковый контейнер, можно с ручкой. Во время мочеиспускания собаки его лишь нужно аккуратно подставить под неё, стараясь не напугать своими действиями. После взбалтывания мочи (она не должна потерять осадок) её переливают в лабораторную баночку и направляют на анализ. Объём собранной жидкости должен составлять не менее 2 мл.

Общий анализ мочи — информативный метод диагностики, поэтому, несмотря на сложность сбора биоматериала, владелец не должен игнорировать его. Ответственный подход к обследованию питомца позволит определить истинную причину тех или иных нарушений и избежать осложнений имеющихся заболеваний в будущем. Это должно быть интересно любому ответственному хозяину собак.
помогла
